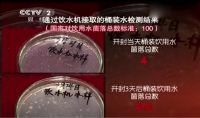
碧水源净水带您探寻桶装水换成直饮水热潮背后的奥秘

[家居资讯] 小米有品众筹超400万完美收官!小猴出品,必属爆款!
08/31/2020 18:34
伴随着偶尔吹起的凉风与逐渐进入终章的热门综艺,2020的火热夏季已然接近尾声。 而小猴直柄电动螺丝刀,这款伴随小米十周年一起在小米有品开启众筹的新品,热度丝毫不输这个夏季,以累计总额破40...
>> 查看全文
[家居资讯] 2019大宅设计师年度新势力榜盛典成功举办
08/31/2020 18:33
2020年8月21日,由金堂奖全国联盟与满京华·国际艺展中心联合举办的“2019中国大宅设计师年度新势力榜"颁奖典礼与思想论坛活动,在...
>> 查看全文
08/31/2020 18:20
2020年5月,寐MINE与美克美家正式签订15家主力门店联营合同。 美克美家从创立之初就秉承着“高品位、经典、浪漫、优雅”的品牌价值主张,通过美克家居强大的制造业及供应链背景,近年来不断通过全新...
>> 查看全文
[家居资讯] 碧水源净水带您探寻桶装水换成直饮水热潮背后的奥秘
08/31/2020 18:06
桶装水曾一度被认为是一种便捷、时尚的饮水方式,但近些年,尤其是今年新冠肺炎疫情爆发以来,越来越多的人对桶装水叫停,对家里的饮水方式进行升级,采用了更安全、更健康、更便捷的直饮水。针对这种&quo...
>> 查看全文
[家居资讯] 名雕佰恩邦丨都市新贵的家,这么装尽显高端大气!
08/31/2020 18:02
图丨名雕佰恩邦全屋装——醇·享受 新房装修怎么来好?很多人买了新房之后就开始愁装修,自己懂装修的最好,自己不懂的愁坏了,不知道装修出来的家怎么样?装修市场又鱼龙混杂,怕装修套路多,怕...
>> 查看全文